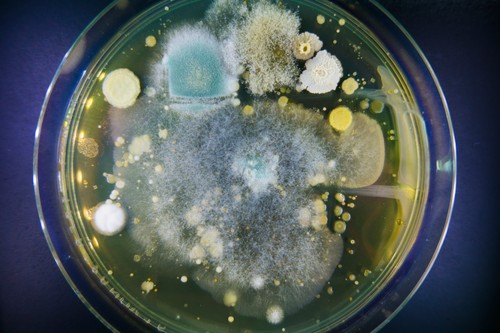
Petri dish with bacteria

Smrtonosna bakterija prvi put otkrivena u vodi, CDC izdao upozorenje
Potencijalno smrtonosna vrsta bakterije koja je dosad viđena samo u južnoj Aziji, Africi i Australiji po prvi put je otkrivena u uzorcima tla i vode prikupljenima u SAD, priopćio je u srijedu američki CDC.
Oglas
Bakterija, koja se zove Burkholderia pseudomallei, može dovesti do oboljenja nazvanog melioidoza, za koju se zna širom svijeta da može dovesti do smrti.
U SAD-u se zabilježi desetak slučajeva melioidoze godišnje, i to obično kod ljudi koji su prije tog boravili u inozemstvu, piše NBC News.
"Nejasno je koliko je dugo bakterija prisutna u okolišu"
Međutim, u srijedu je CDC objavio da je bakterija nađena u uzorcima tla i vode prikupljenima uz obalu Meksičkog zaljeva u državi Mississippi, te je izdao zdravstveno upozorenje svim liječnicima u Americi da obrate pažnju na moguće znakove melioidoze, koji mogu biti nejasni i koji mogu uključivati kašalj, povišenu temperaturu, i bol u prsima. Kod težih slučajeva bolest može dovesti do dezorijentacije, simptomima sličnim upali pluća, kao i napadaje poput onih kod epilepse.
“Nejasno je koliko dugo je bakterija prisutna u okolišu i gdje bi još u SAD-u mogla biti,” navodi se u priopćenju CDC-a.
Dr. Jill Weatherhead, profesorica tropske medicine i zaraznih bolesti sa medicinskog fakulteta Baylor u Houstonu, je rekla da dolazak bakterije u SAD ne iznenađuje.
“Ovdje u Americi, duž obale Meksičkog zaljeva, imamo suptropsku klimu, ovdje je toplo i vlažno. A to je okolina idealna za Burkholderiju pseudomallei,” rekla je.
Gdje je otkrivena bakterija?
Bakterija bi se potencijalno mogla proširiti bilo gdje uz obalu Meksičkog zaljeva, gdje bi mogla postati endemska, dodala je.
Bakterija je otkrivena u SAD-u nakon što su dvijema osobama koje nisu bile u srodstvu ali su živjele blizu jedna drugoj u Mississippiju liječnici dijagnosticirali da boluju od melioidoze - prvoj 2020. i drugoj 2022. godine.
Po upozorenju koje je liječnicima uputio CDC, obje osobe su završile u bolnici zbog sepse nakon što su dobile upalu pluća. Obje su liječene antibioticima i zatim se oporavile.
N1 pratite putem aplikacija za Android | iPhone/iPad i društvenih mreža Twitter | Facebook | Instagram.
Kakvo je tvoje mišljenje o ovome?
Pridruži se raspravi ili pročitaj komentare
Oglas
Kakvo je tvoje mišljenje o ovome?
Pridruži se raspravi ili pročitaj komentare
Oglas
NAJČITANIJE
Oglas
Oglas
Najnovije
Oglas
Oglas